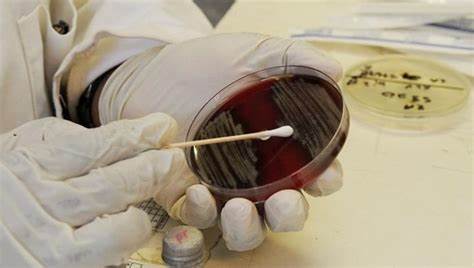
医生|4种药物很便宜,医生家中常备,但是药店从来不主动推荐

医生|4种药物很便宜,医生家中常备,但是药店从来不主动推荐

文章图片

文章图片
文章图片

文章图片

这多稀罕啊 , 谁没去药店买过药啊?
你去药店买过药吗?
可是弱弱地问一下 , 你去药店买药的时候 , 体验是不是都有些怪怪的呢?
很多时候我们去药店买药 , 店员都会日常询问一下是什么症状 , 然后给一些推荐 。
当然 , 并没有多少人真的了解自己的疾病 , 也不知道自己的用药是否符合标准 , 但是相对来说 , 店员可能会更有经验一些 。
于是稀里糊涂地就买了 , 不过结账的时候 , 很多人心里都会有些不舒服 。
其实 , 这种原因是很多方面的 。
“明明说药品改革了都降价了 , 为什么自己每次买药还要花那么多钱呢?”
首先跟大家强调一个事实 , 药品虽然改革了 , 但并不是说所有药品的价格都降下来了 , 有一些比较好的药确实还很贵 。
什么是比较好的药呢?当然好坏是相对而言的 , 好药并不一定是你想象中的那种好 。
对于医生而言 , 药物的好坏是差异很大的 。
比如有些抗生素 , 像红霉素 , 虽然效果很不错 , 但是对临床中的很多细菌都不敏感 , 用起来很不顺手 , 甚至会使病情加重 。
可是相对而言 , 比较昂贵的替加环素对一些耐药菌就十分敏感 , 只要用几天细菌感染就可以搞定 。
贵的药 , 确实有贵的价值 。
但这只是相对而言 , 并不是所有昂贵的药都值得我们出大价钱 。
上面所举的例子只是很罕见的情况 , 在生活中我们并不需要用这么昂贵的药物来治疗疾病 , 很多常用药便宜药效果也都很好 。
疾病和疾病不一样 , 药物和药物差距也很大 。
可是同样的一类药物 , 店员仍然会推荐价格高一点的 , 毕竟他的工作薪酬和药物价格也有一些关联 。
相信对大多数人而言 , 只要不是谋财害命 , 稍稍赚点钱也是可以被人理解的 。
可是面对医生 , 很多店员就束手无策了 , 因为这类客户对药品确实很了解的 , 去药店买药的时候也不用多问 , 医生往往会准确地说出药品的名称直接购买 。
其实 , 有一些药物很多医生都了解 , 家里都是常备的 , 但更重要的是这些药物并不昂贵 , 只需要几块钱就可以搞定 。
今天就来推荐4种药物 , 很多医生家里都会常备 , 但是都不贵 。
一、奥美拉唑 。你吃过奥美拉唑吗?
其实很多胃不好的人 , 医生都会建议使用奥美拉唑 , 这是一种非常常见的药物 。
奥美拉唑在临床中的应用已经很多年了 , 我们一直把它视为胃肠道疾病的一线用药 。
当然在药物的研发当中已经有了很多迭代产品 , 不过奥美拉唑的地位始终稳固 , 对于很多胃部不适症状奥美拉唑的效果都是很好的 。
但是 , 奥美拉唑很便宜吗?
要知道对于奥美拉唑来说 , 已经度过了药物保护期 , 很多国产的奥美拉唑效果也是很不错的 , 不过对于现在的药品而言 , 奥美拉唑有很多种类型 , 很多个厂家都有自己的产品 。
- 排毒|女性要排毒,推荐多吃4种食物,养护皮肤,祛皱美容,血管更通畅
- 卫生室|《乡村医生诊疗口袋书(先行本)》面世
- 温阳|医生使用这种儿童禁用药致患儿过敏死亡,被判赔偿34万丨医法汇
- 肠镜|肠镜选无痛好还是普通好?二者有何区别?不妨听听医生的分析!
- 需求|预约诊疗 | 齐齐哈尔市中医医院1月17日—1月23日医生出诊一览表
- 一喝水,尿就多,是代表肾脏好还是不好?听听医生的分析
- 问题|常年抽烟没异常,戒烟后却浑身难受,怎么回事?医生说出了原因!
- 夜间常口渴,嘴巴发苦,或是4种疾病的出现,可惜多数人忽视了!
- 失眠者|长期失眠等于慢性自杀!医生建议:6种食物多吃点,帮你找回睡意
- 伯伯|“ 等我长大了,也要当像您一样的医生 ”
